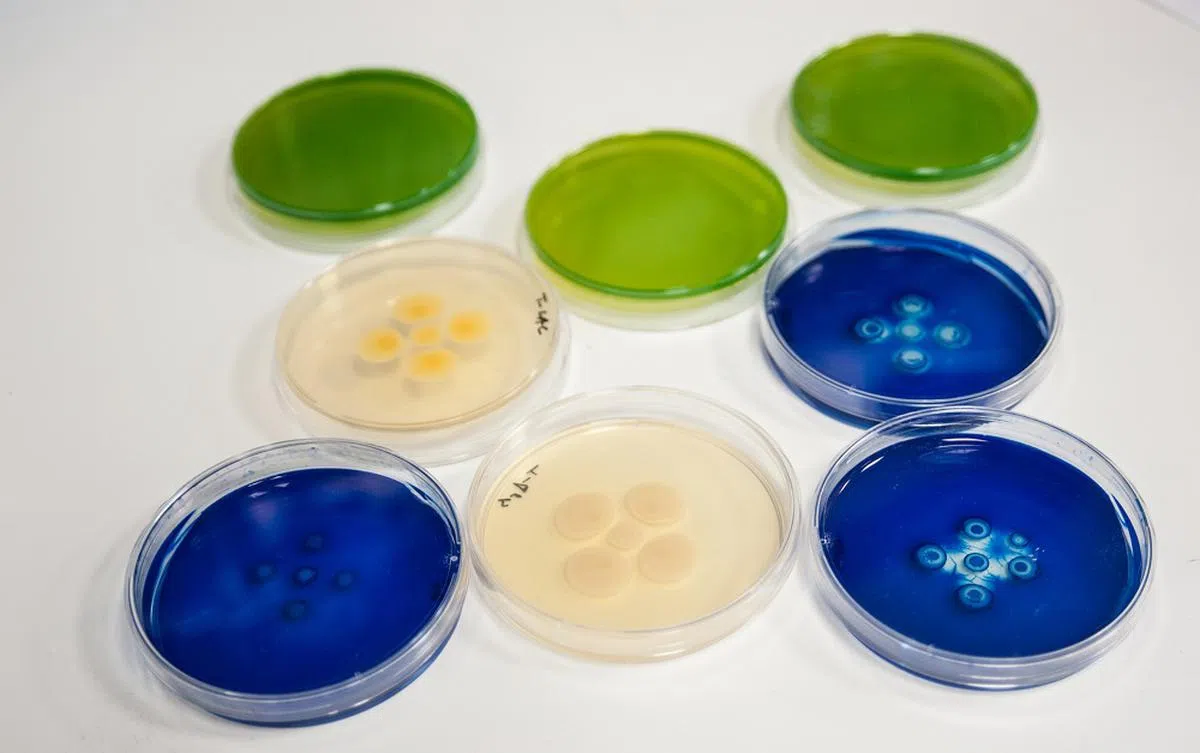
不当使用或过量服用抗生素，可能导致细菌变异成“超级细菌”。图为西班牙实验室培植的“超级细菌”。（CSIC西班牙国家研究理事会）

病了若想快点康复 不要随便跟医生讨抗生素

抗生素不是万灵药
“医生,我感冒咳嗽很多天了,可以给我抗生素(antibiotics)吗?”
这个问题,相信很多新加坡医生都听过,也不厌其烦地向病人解释过。
然而,提出这类问题的病人却有增无减,当中不少还是20多岁的年轻人。
新加坡国立大学综合诊疗所近日发表了首个大规模抗生素调查结果。从2018年到2021年,在新加坡六家综合诊疗所的320万次门诊中,医生共开出25万次抗生素处方:
全科医生蔡源吉接受亚洲新闻台访问时坦言:
“一些病人会向医生施压,强迫我们开抗生素。可能他们急着回去上班或希望孩子快点康复,而需要一个快速解决方案,但这不是管理疾病的正确方式。”
他举例说,如果病人只有轻微的感冒症状,而且病了一两天,通常只是病毒感染,服用抗生素也无济于事。
细菌 病毒 傻傻分不清楚
重点来了:
抗生素是用来治疗细菌感染(bacterial infection),不是病毒感染(viral infection)。
那要怎么知道自己的病是细菌感染还是病毒感染呢?这就有赖医生的经验、知识和专业判断了。
抗生素之所以叫抗生素,是因为细菌是活细胞微生物,抗生素可以破坏细胞膜,杀灭细菌。
不过,病毒不是细胞,它的表层由蛋白质包裹,就连抗生素也拿它没办法。
以下这些常见疾病,可别搞混了!


细菌越变越“强大” 可用抗生素却越来越少
蚁粉有没有发现,医生开抗生素时都会再三提醒:
“一定要完成整个疗程,不要把吃剩的抗生素留到以后生病再吃。”
如此苦口婆心,其实是为了避免产生耐药性(antimicrobial resistance)。
不当使用或过量服用抗生素,都有可能增加细菌对抗生素的耐药性,甚至导致细菌变异成“超级细菌”,到时就更难把病治好了。
卫生部指出:
“一旦细菌对抗生素产生耐药性,病患须要服用更昂贵的新一代药物。这会拉长治疗和住院时间,并推高医药费,可能还会产生更多副作用。”
在新加坡,引起尿道感染的细菌已产生高达20%的耐药性,也就是说,本地的尿道感染问题越来越难治好。
当原有的抗生素药效减弱,就必须增加药量或改用更强效的抗生素,否则可能会引起严重的并发症。
据统计,2019年全球有127万人死于抗生素耐药性的细菌感染,495万人死于相关的并发症,远超过每年死于疟疾或爱之病的人数。
预计到了2050年,与抗生素耐药性有关的死亡病例可能多达1000万人,相当于每三秒就有一人死亡。
世界卫生组织已把抗生素耐药性列为“全球十大公共卫生威胁之一”。
坏消息是,随着细菌越来越“强大”,可使用的抗生素却越来越少,因为全球过去30年都没有研发出新的抗生素。

研发一款新的抗生素需要数十年时间,成本极其昂贵,带来的潜在利润却相对较低,因此这种“无利可图”的研发工作多数都由小型药剂公司进行。
既然世界卫生组织鼓励医疗人员尽可能少用抗生素,以免细菌产生耐药性,这些制药商怎么还会有意愿研发新的抗生素呢?
抗生素可能导致婴儿肥胖?
新加坡国立大学杨潞龄医学院的另一项研究也发现,少过一岁的婴儿若过早接触抗生素,可能增加儿童期的肥胖风险。
研究显示,若在未满周岁前服用一个疗程的抗生素,幼童从一岁三个月至五岁面对的肥胖风险,将是未服用幼童的1.45倍;若服用至少三个疗程的抗生素,风险则是2.78倍。
研究团队解释,人类的肠道依靠微生物来提供必需营养以帮助消化,但抗生素可能破坏肠道菌群的生态系统,消灭不少有益菌,留下的有害菌可能会导致肥胖问题。
卫生部早在2006年已推出有关抗生素的指导原则,之后于2011年在医院推行抗菌药物管理计划,指导医生如何使用抗生素减缓超级细菌的滋长。

不过,蔡源吉医生认为,除了医生的专业判断,纠正病人对抗生素的误解也很重要。
“不论开或不开抗生素,医生都应该向病人解释原因。”
抗生素不是什么万能的灵丹妙药,也不是为了“以防万一”而打的预防针。想要快点康复,还是听医生的话吧!